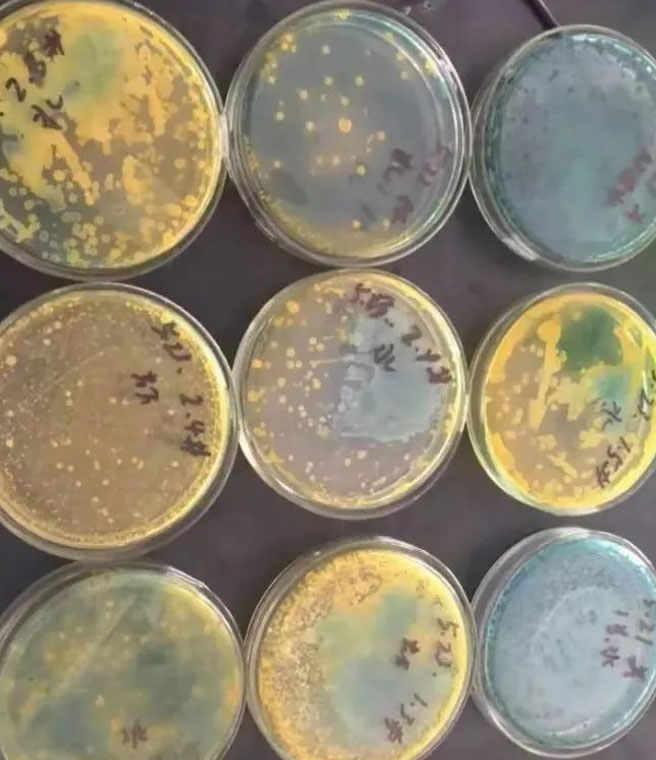
how-to-tackle-the-number-one-enemy-of-litopenaeus-vannamei-vibrio-disease1.jpg
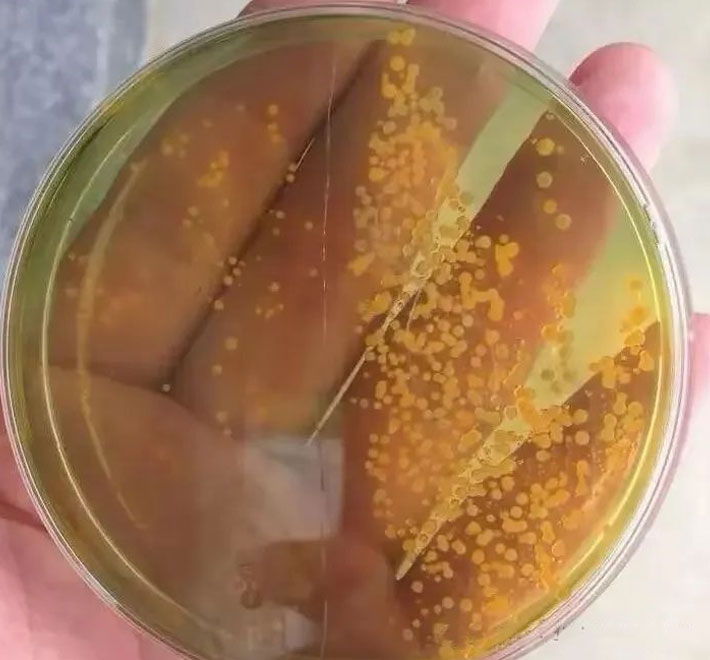
how-to-tackle-the-number-one-enemy-of-litopenaeus-vannamei-vibrio-disease3.jpg

In shrimp aquaculture, one of the most troublesome enemies is Vibrio bacteria. These harmful microbes thrive in pond environments and can cause serious problems, including early-stage hepatopancreatic necrosis, empty intestines and stomachs, and even sudden shrimp deaths. Whether in small tanks or large ponds, poor water quality and heavy feeding make shrimp farms especially vulnerable to Vibrio infections.
Vibrio are small, curved bacteria with a tail-like flagellum that helps them move. They are anaerobic, meaning they grow well in low-oxygen environments. Several species are harmful to shrimp, including:
1. Vibrio alginolyticus – Tolerates high salinity (5‰–50‰) but not freshwater. It causes ulcers, red body color, rotten gills, and soft shells.
2. Vibrio parahaemolyticus – Thrives in warm (30–37°C), salty water. It causes cloudy bodies, swollen hepatopancreas, loss of appetite, and empty stomachs.
3. Non-O1 Vibrio cholerae – Grows in both fresh and salty water. Infected shrimp move slowly, float on the surface, and show muscle whitening before death.
4. Vibrio harveyi – Prefers warm water (around 37°C). Infected shrimp stop feeding, sink to the bottom, and may show bioluminescence before death.

Several environmental factors promote Vibrio growth in shrimp ponds:
· Dead or decaying algae – Algal blooms followed by die-offs create foul organic matter, perfect for Vibrio.
· Shrimp waste and leftover feed – Organic matter accumulates at the pond bottom, becoming a breeding ground.
· Raw organic fertilizers – Manure and compost may carry Vibrio unless treated with lime first.
· Excessive use of zeolite or dolomite – These can trap harmful substances at the bottom, leading to toxic byproducts like ammonia and sulfides.
· Polluted water sources – Bringing in contaminated water during exchange introduces Vibrio directly.
When these problems combine, the result is low oxygen, foul odors, and explosive bacterial growth—leading to infection.
Because Vibrio cannot be completely eliminated, the best approach is prevention and control:
1. Manage water quality – Regularly remove sludge, balance algae levels, and avoid poor-smelling pond bottoms.
2. Strengthen shrimp health – Healthy shrimp are more resistant. Use vitamins, polysaccharides, and probiotics to improve immunity.
3. Control stocking density – Avoid overcrowding, which stresses shrimp and worsens water quality.
4. Disinfect carefully – Use safe disinfectants like potassium monopersulfate compound or chlorine dioxide when Vibrio levels rise. Always follow with beneficial bacteria (such as lactic acid bacteria) to restore microbial balance.
5. Regular monitoring – Vibrio grows fast. Detect early using TCBS agar tests before bacteria reach dangerous levels.
· In outdoor ponds: Focus on prevention—maintain water and soil quality, reduce organic matter, and manage algae.
· If Vibrio levels spike:
o Day 1: Give multivitamins (morning) and disinfect with potassium monopersulfate (afternoon).
o Day 2: Disinfect again to target bacteria on pond surfaces.
o Day 3 onward: Add probiotics and immune boosters (e.g., lactic acid bacteria, yeast polysaccharides, vitamins) for 5–7 days.
· In indoor farming systems: Disinfect regularly (after about 35 days of culture), then replenish beneficial bacteria to maintain balance.
Vibrio is one of the biggest threats to shrimp aquaculture. While it cannot be completely eradicated, shrimp farmers can control its numbers by improving water quality, reducing organic waste, boosting shrimp immunity, and using probiotics after disinfection.
Prevention, rather than treatment, is the most effective strategy for keeping shrimp healthy and farms productive.